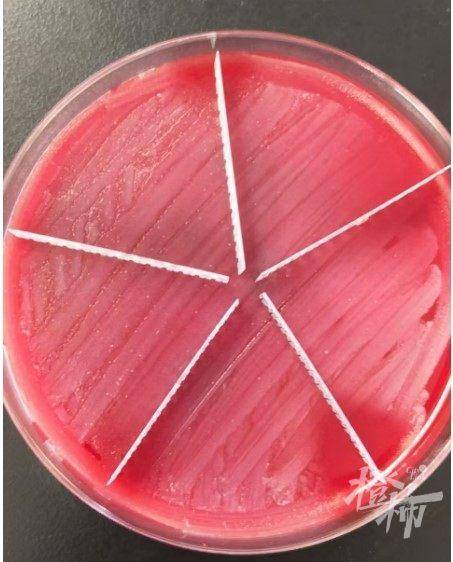

双下巴、拜拜肉、小肚子、大象腿……只要打一针,统统没有了,整个人暴瘦一圈!真有这种好事?
25岁的小美(化名)毕业不久后,就来到了杭州从事直播工作,由于容貌姣好,又勤快肯干,很快吸引了不少的粉丝。然而,随着关注的粉丝越来越多,负面的声音也多了起来。
“你太胖了吧!”“主播,你能跳得动吗?”“这么胖,看来我也能当主播”……诸如此类的负面声音让小美越来越自卑,摸着肚子上的“游泳圈”,她决心要快点瘦下来。
或许是求瘦心切,小美点开了某美容机构的咨询页面,当得知有一种快速瘦身的“减脂神器”时,她立刻两眼放光。
销售说起来,这个叫做“溶脂针”,一针就能瘦,想瘦哪里瘦哪里,还有不开刀、不麻醉、见效快、无恢复期等多种优点,基本上符合小美的需求了!
没等到变瘦,却已“千疮百孔”
没有过多犹豫,小美急忙赶到美容机构,付款、预约时间,准备迎接全新的自己。为了一次达到满意效果,小美直接选择了全身溶脂,也就是溶脂针要打满全身,而且一个疗程最少要打三次。
结果疗程没结束,还没看到曲线的变化,小美就感到全身乏力疼痛。尤其是注射部位,像无数只蚂蚁在撕咬着皮肤,但小美却被销售告知是正常现象。心想这是变美的必经之路,她只好继续忍着痛坚持。

然而,随着时间的推移,小美发现注射部位的皮肤爆出了一个个血泡,还有奶油样的分泌物流出,同时低热、乏力的症状更严重了。无奈之下,她全身裹着纱布,来到了杭州市第一人民医院。
市一医院医疗美容科医生为她做了脓液清创引流手术,同时第一时间将脓液送细菌培养。一周后脓液培养结果赫然显示“脓肿分枝杆菌”!
小美怎么会感染脓肿分枝杆菌?
由于脓肿病变是由溶脂针注射点发展而来的,医生怀疑感染可能是由于不规范的无菌操作和注射、手术、设备污染或术中感染,或是注射产品不符合国家规定标准的卫生材料等引起的。
医源性感染已成为脓肿分枝杆菌感染快速增长的常见原因之一,这种感染会给患者带来极大痛苦。好在,感染内科朱婧副主任医师会诊后,根据相应的药敏结果选择了三联抗生素抗感染方案,在配合医疗美容科积极的清创引流以及强效敏感抗生素的使用。
小美的病情逐渐好转,皮肤创口的脓液也渐渐少了。出院后按照医嘱口服将近4个月的抗生素,皮肤的脓肿才完全吸收愈合,身体却留下了几十道触目惊心的疤痕。
这种针没有合法身份,真的不能打!
医疗美容科主任李金晟表示,目前医美市场所谓的“局部注射溶脂针”在中国并没有获得食品药品监督管理部门的核准,中国的药监网也查询不到该类药品信息,安全性无从谈起,后续维权也困难重重。
目前,杭城不少大型三甲公立医疗机构都设有医疗美容科、整形外科等临床科室供求美者选择。无论是医美技术还是并发症处理,均有强有力的医疗团队保驾护航。希望广大爱美人士能够擦亮眼睛,理性医美。
选择医疗美容时,大家要注意以下几点:
一看资质。
正规美容医疗机构应持有《医疗机构执业许可证》。
二看人员。
实施医疗美容项目的人必须持有《医师执业证书》,同时还必须是“医疗美容主诊医师”。
三看环境。
医疗美容项目要在医疗机构的手术室或治疗室进行。
四看流程。
正规的医疗美容机构,应当由医师接诊患者并如实书写病历,在实施医疗美容项目前,向患者告知具体方案和风险,签署书面知情同意书。
五看药械。
医疗美容应使用符合国家标准的各类药物以及医疗器械等,进口药品和医疗器械必须有中文标识。
(橙柿互动)